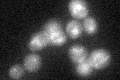
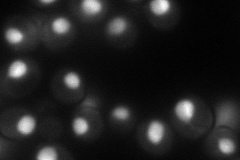
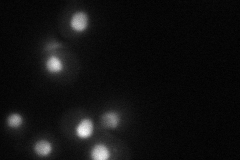
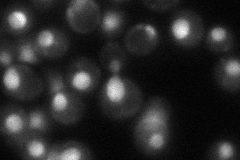
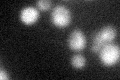
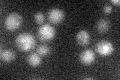

View description
Methyltransferase, methylates residue G1575 of 18S rRNA; required for rRNA processing and nuclear export of 40S ribosomal subunits independently of methylation activity; diploid mutant displays random budding pattern
Localization:
Intensity:
Fold change:
Significance:
-
C’ GFP library in SD
ambiguous25.56 -
N' NOP1pr-GFP in SD
nucleus97.9015 -
N' TEF2pr-mCherry in SD
nucleus39.8345 -
N' NATIVEpr-GFP in SD
nucleus51.6474 -
N' TEF2pr-VC and Cyto-VN in SD

nucleus31.0305 -
C’ GFP library in SD+DTT
ambiguous21.120.82No -
C’ GFP library in SD+H2O2

ambiguous22.380.87No -
C’ GFP library in Starvation Media
ambiguous22.370.87No -
C’ GFP library on the background of Pup2-DaMP

ambiguous -
C’ GFP library on the background of CCT mutant

ambiguous22.73920.889411No
